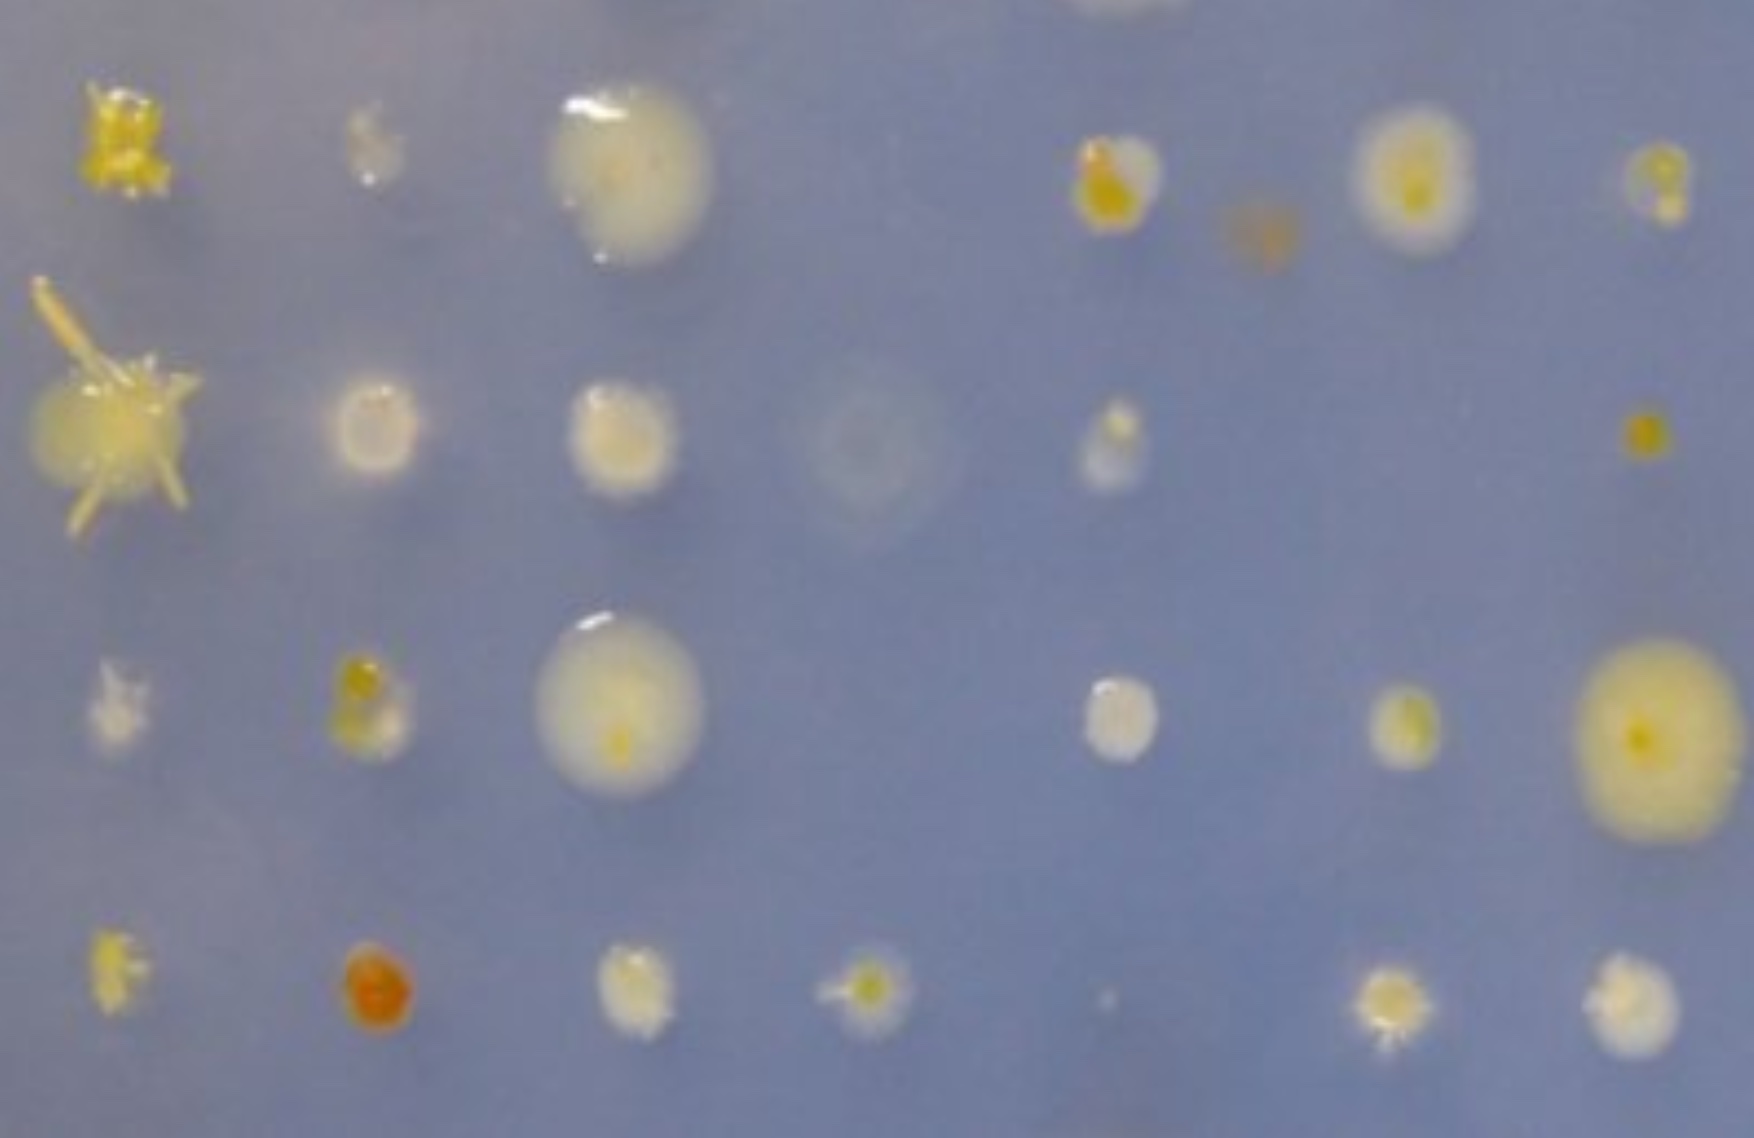

Methoden

Wir sind immer auf der Suche nach spannendem Detailwissen über einzelne Mikroben, aber auch ganze Ökosysteme. Das Erbmaterial von Mikroben beispielsweise, die DNA, birgt viel Information über deren Lebensstil und Fähigkeiten. Um Mikroben genau zu untersuchen, um ihrer DNA, ihren Enzymen, ihren biochemischen Fähigkeiten auf die Spur zu kommen, verwenden wir viele unterschiedliche Methoden. Hier stellen wir eine Auswahl der Methoden unseres Instituts vor.
Zuckeranalyse
Hier haben wir uns einen kompetenten Lehrmeister gesucht: Zuckerabbauende Bakterien. Jedes Bakterium hat eigene Enzyme, seine eigenen Werkzeuge, um Polysaccharide (Mehrfachzucker) aufzubrechen und in kleinere, einfachere Einheiten zu zerschneiden. Dieser Mechanismus steht im Fokus des Verfahrens, denn diese Einfachzucker sind leichter zu messen als Polysaccharide. Mehr...
Analyse mikrobieller Metabolismen
Hier geht es um die Analyse von Enzymen, die die Umwandlung von Mineralien und Gasen katalysieren. Wir entnehmen diese Enzyme und trennen sie von anderen Proteinen, indem wir sie direkt aus dem nativen Organismus aufreinigen. Danach entschlüsseln wir die molekularen Geheimnisse der chemischen Reaktionen via Röntgen-Kristallographie. Das bedeutet, dass wir die Enzyme zunächst kristallisieren, um anschließend Röntgenstrahlen verwenden zu können, die uns Bilder unserer Enzyme liefern. Mehr...
Metagenomik
Mithilfe der Metagenomik wird es möglich, eine Umweltprobe – also einem Gemisch verschiedenster Organismen, wie sie in der Umwelt zusammenleben – zu analysieren und zu erfahren, welche Organismen darin leben und welche Gene und damit Stoffwechselwege, Interaktionen oder Verteidigungsstrategien sie beherrschen. Mehr...
Fluoreszenz-in-situ-Hybridisierung (FISH)
Mikroorganismen kann man ihrem Aussehen nach kaum unterscheiden. Dennoch hat jede Zelle ihren eigenen Fingerabdruck, der typisch für jede Art ist – das Erbmaterial. Ein Fall für FISH, die „Fluoreszenz-in-situ-Hybridisierung“. Sie macht bestimmte Abschnitte des Erbmaterials einzelner Zellen sichtbar. Unter dem Mikroskop werden diese Zellen dann zum Leuchten gebracht. FISH-Bilder von Mikroorganismen sehen aus wie ein Sternenhimmel, nur in verschiedenen Farben. Unsere Frage ist: Was erstrahlt wo? Mittels FISH können wir die Organismen in unseren Proben genau identifizieren. Mehr...
Isolierung und Kultivierung von Mikroorganismen
Wir verdünnen frisch genommene Umweltproben direkt nach der Probenahme mit sterilem Seewasser, um einzelne Zellen zu isolieren. Und wir inkubieren für lange Zeiten, um auch langsam wachsende Zellen zu erhalten. Die Kombination von physikalischer Vereinzelung in Hunderte von Kulturen, genügend Zeit für Wachstum und molekulare Techniken zur Analyse der Anreicherungskulturen benötigt zum Erfolg das perfekte Medium. Mehr...